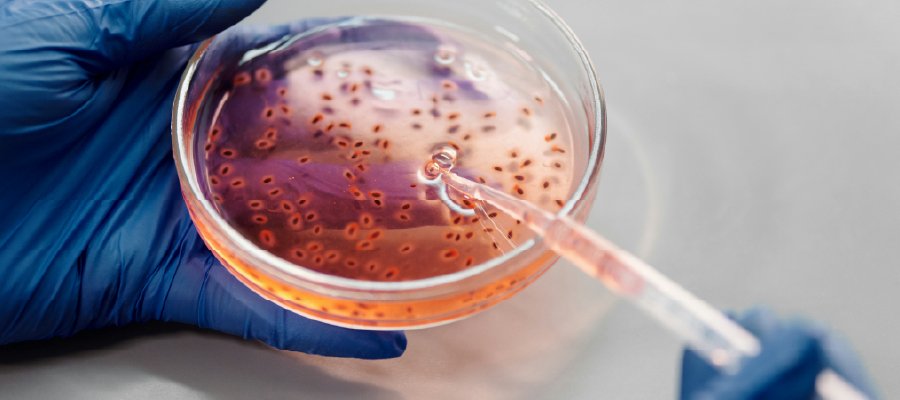

Empowering Innovation in Life Sciences with Legal Precision
At LCS Fields, we support pharmaceutical companies, biotech startups, healthcare providers, and research institutions by offering strategic legal guidance tailored to the fast-evolving life sciences ecosystem.
Our legal solutions ensure compliance with complex regulatory regimes, protect intellectual assets, and manage risk across R&D, clinical trials, licensing, and global market access.
- Regulatory compliance for pharmaceuticals and medical devices
- Clinical trial agreements and data governance
- IP protection for biotech innovations
- Licensing, technology transfer, and joint ventures
- Telemedicine and cross-border digital health compliance
- M&A and financing in health and biotech sectors
